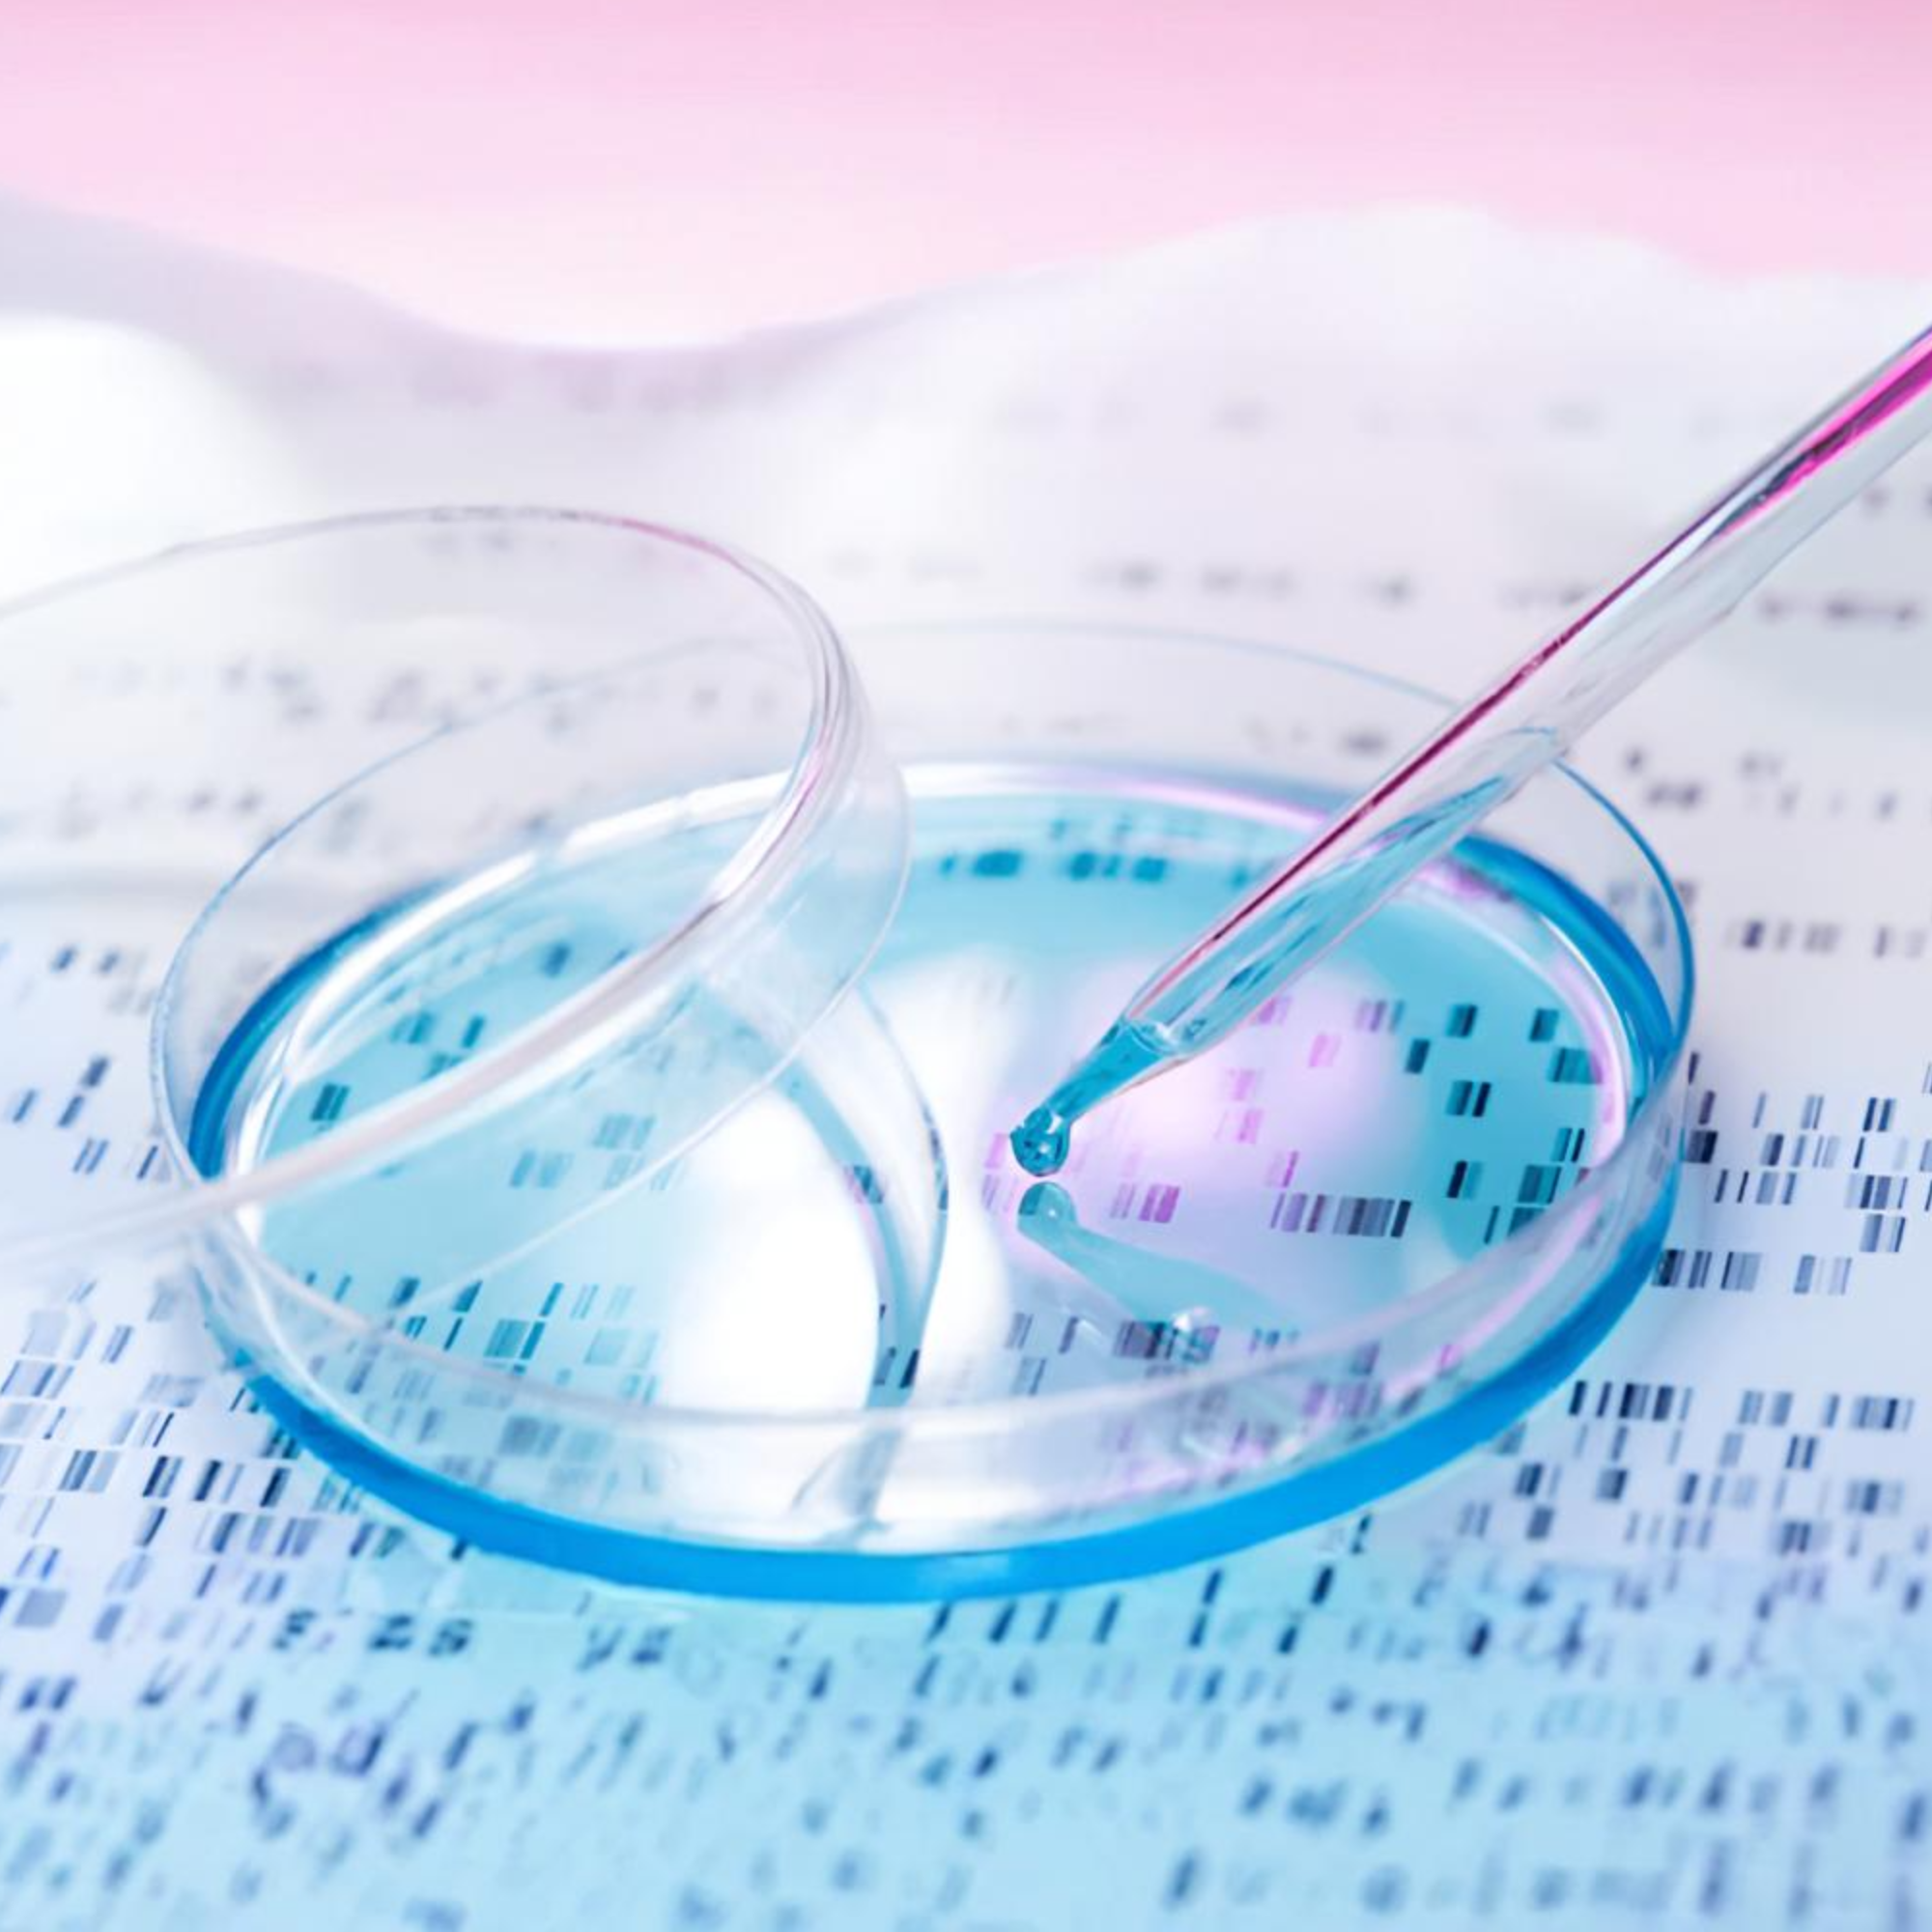
Buy Dry Ice Petri dish

Food & Perishable Shipping
Research & Biomedical Uses
Restaurants & Event Solutions
Camping & Keeping Drinks Cool

Camping with Dry Ice
Start your next camping trip out right with dry ice in the cooler! Dry ice lasts longer than traditional ice and doesn’t melt into a liquid form! It can keep frozen items from thawing and spoiling which can come in handy when on long trips! Read this post before you pack your cooler with dry ice!
Need Help? Explore Our FAQs
What is Dry Ice
What is Dry Ice
Dry ice is a name that is applied to compressed carbon dioxide, “snow.”
Does it Melt
Does it Melt
No. Dry ice goes through a process called “sublimation” in which a solid substance skips the liquid state and changes directly into a gaseous state.
Dry Ice Safety - Important
Dry Ice Safety - Important
Dry ice is extremely cold, cold enough to freeze skin cells and cause an injury similar to a burn. Always handle dry ice with protective gloves. If you don't have gloves, you could also use a towel or oven mitt -- anything that acts as a buffer between your skin and the dry ice.
How to pack a cooler with Dry Ice
How to pack a cooler with Dry Ice
1.Place Dry Ice at the bottom of your insulated cooler
2.Place newspaper or cardboard over the top of the dry ice
3.Layer regular ice over the top
4.Add items to be chilled
5.Pour regular ice over the top of the items
6.And enjoy your cold beverages and keep your food cold!
We Deliver to a 25km ring of Melbourne